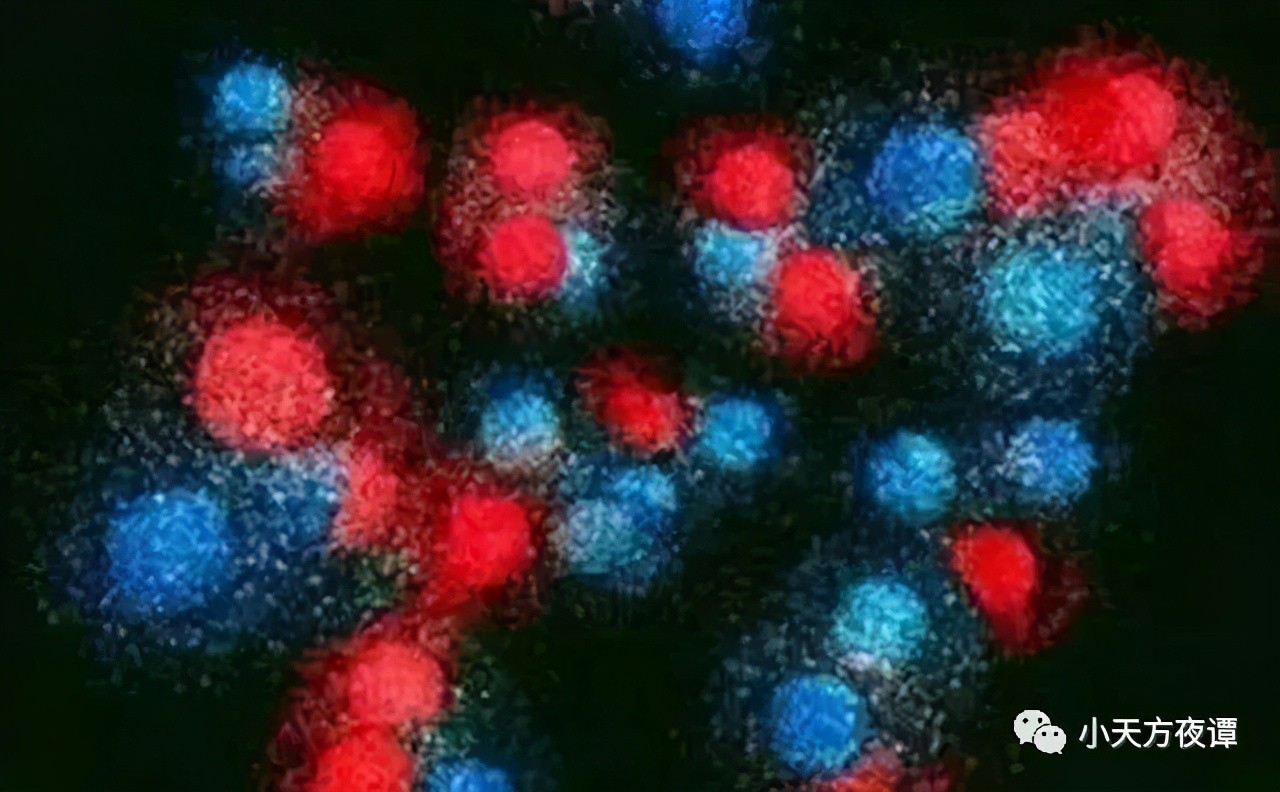

千禧年数学七大难题、Science发布最前沿125个科学问题
千禧年数学七大难题、Science发布最前沿125个科学问题
千禧年数学七大难题
小天知道“千禧年数学七大难题”,每个难题都价值一百万美金,谁能解决其中一个,必定是数学史上最杰出的数学家之一。
2000年5月,由美国富豪出资建立的克雷数学研究所(Clay Mathematics Institute, 简称CMI),精心挑选了七大未解数学难题。任何人只要解决其中一题,都可以领走高达一百万美金的奖金。这七道题也被称为“千禧年数学七大难题”。
可如今20年过去了,七道难题还剩下六道未解。唯一已经被攻破的是曾经困扰人类近百年的“庞加莱猜想”。用大众化可以理解语言可以定义为:在一个三维空间中,假如每一条封闭的曲线都能收缩成一点,那么这个空间一定是一个三维的圆球。1904年,被誉为最后一个百科全书式的法国科学家庞加莱提出了这一猜想。庞加莱猜想”拓扑学的基础难题,如果破解了这个难题,人类对于宇宙和空间的认识将更上一个深度。
这个难题被俄罗斯天才数学家格里高利·佩雷尔曼解决了,他与德国的彼得·舒尔茨并列为世界上最顶级的青年数学家,这两位都获得了数学界最顶级的菲尔兹奖。下图依次是佩雷尔曼、舒尔茨:


在2006年的国际数学奥林匹克竞赛(IMO)中,出现了两个金牌得主,一位是中国的柳智宇,一位是德国的彼得·舒尔茨。这两位数学天才均是满分夺得IMO金牌,据说柳智宇的解题思路还更胜一筹。或许中国的柳智宇也有机会能成长为顶级的青年数学家,可惜柳智宇选择了自己的人生道路,现在是龙泉寺的僧人,法名贤宇。

还有一位华裔的青年天才数学家,叫陶哲轩(澳大利亚),也拿了菲尔兹奖,数学界认为他应该比佩雷尔曼和舒尔茨差一点点。

“千禧年数学七大难题”剩下的六题分别是:杨-米尔斯存在性和质量间隔、贝赫和斯维讷通-戴尔猜想、NS方程解的存在性与光滑性、P/NP问题、霍奇猜想、黎曼猜想。
小天之前的一篇文章(量子霸权有多可怕?中国弯道超车的希望!可抵御黑客攻击破解密码 )里介绍了,黎曼猜想是人类数学科学上的皇冠,当之无愧唯一的最高峰,也代表了人类智慧的最巅峰。小天大胆预测,解决黎曼猜想之人,或许是近千年人类的最强大脑。
这样一个数学猜想,在162年的时间内,人类精英数学家们都没有完全能证明。目前数学界已公开的最好的结果,大概是黎曼ζ函数前十万亿个零点位于临界线上。由两位精通分布式计算与解析数论的专家共同利用超级计算机完成了这个项目。
2018年,著名的数学家迈克尔·阿蒂亚曾公布说自己证明了黎曼猜想,不过后来,被数学界推翻了他的证明。小天希望近十年内能看到有人类精英能证明黎曼猜想。
Science发布全球最前沿的125个科学问题
小天刚看到的这125个科学问题,立刻分享给大家,其中也涉及了“千禧年数学七大难题”中的六个(125个中的最后6个)。最后两个问题,一个是数学的皇冠,一个是量子物理的顶峰。
在庆祝SCIENCE创刊125周年之际,该刊杂志社公布了125个最具挑战性的科学问题。简单归纳统计这125个问题,其中涉及生命科学的问题占46%,关系宇宙和地球的问题占16%,与物质科学相关的问题占14%以上,认知科学问题占9%。其余问题分别涉及数学与计算机科学、政治与经济、能源、环境和人口等。在今后1/4个世纪的时间里,人们将致力于研究解决这些问题。其中,前25个被认为是最重要的问题。

125个问题如下:

1、宇宙由什么构成?

2、意识的生物学基础是什么?

3、为什么人类基因会如此之少?

4、遗传变异与人类健康的相关程度如何?

5、物理定律能否统一?

6、人类寿命到底可以延长多久?

7、是什么控制着器官再生?

8、皮肤细胞如何成为神经细胞?

9、单个体细胞怎样成为整株植物?

10、地球内部如何运行?

11、地球人类在宇宙中是否独一无二?

12、地球生命在何处产生、如何产生?

13、什么决定了物种的多样性?

14、什么基因的改变造就了独特的人类?

15、记忆如何存储和恢复?

16、人类合作行为如何发展?

17、怎样从海量生物数据中产生大的可视图片?

18、化学自组织的发展程度如何?

19、什么是传统计算的极限?

20、我们能否有选择地切断某些免疫反应?

21、量子不确定性和非局部性背后是否有更深刻的原理?

22、能否研制出有效的HIV疫苗?

23、温室效应会使地球温度达到多高?

24、什么时间用什么能源可以替代石油?

25、地球到底能负担多少人口?

26、宇宙是否唯一?

27、是什么驱动宇宙膨胀?

28、第一颗恒星与星系何时产生、怎样产生?

29、超高能宇宙射线来自何处?

30、是什么给类星体提供动力?

31、黑洞的本质是什么?

32、正物质为何多于反物质?

33、质子会衰减吗?

34、重力的本质是什么?

35、时间为何不同于其他维度?
36、是否存在比夸克更小的基本粒子?

37、中微子是其自己的反粒子吗?

38、是否有解释所有相关电子系统的统一理论?

39、人类能够制造最强的激光吗?

40、能否制造完美的光学透镜?

41、是否可能制造出室温下的磁性半导体?

42、什么是高温超导性之后的成对机制?

43、能否发展关于湍流动力学和颗粒材料运动学的综合理论?

44、是否存在稳定的高原子量元素?

45、固体中是否有超流动性?如果有,如何解释?

46、水的结构如何?

47、玻璃态物质的本质是什么?

48、是否存在合理化学合成的极限?

49、光电电池的最终效率如何?

50、核聚变将最终成为未来的能源吗?

51、驱动太阳磁周期的原因是什么?

52、行星怎样形成?

53、是什么引发了冰期?

54、使地球磁场逆转的原因是什么?

55、是否存在有助于预报的地震先兆?

56、太阳系的其他星球上现在和过去是否存在生命?

57、自然界中手性原则的起源是什么?

58、能否预测蛋白质折叠?

59、人体中的蛋白质有多少存在方式?

60、蛋白质如何发现其作用对象?

61、细胞死亡有多少种形式?

62、是什么保持了细胞内的通行顺畅?

63、为什么细胞的成分可以独立于DNA而自行复制?

64、基因组中功能不同于RNA的角色是什么?

65、基因组中端粒和丝粒的作用是什么?

66、为什么一些基因组很大,另一些又相当紧凑?

67、基因组中的“垃圾”(“junk”)有何作用?

68、新技术能使DNA测序的成本降低多少?

69、器官和整个有机体如何了解停止生长的时间?

70、除了继承突变,基因组如何改变?

71、在胚胎期,不对称现象是如何确定的?

72、翼、鳍和面孔如何发育进化?

73、是什么引发了青春期?

74、干细胞是否位于所有肿瘤的中心?

75、肿瘤更容易通过免疫进行控制吗?

76、肿瘤的控制比治愈是否更容易?

77、炎症是所有慢性疾病的主要原因吗?

78、疯牛病会怎样发展?

79、脊椎动物在多大程度上依赖先天免疫系统来抵抗传染病?

80、对抗原而言,免疫记忆需要延长暴露吗?

81、为什么孕妇的免疫系统不拒绝其胎儿?

82、什么与有机体的生物钟同步?

83、迁徙生物怎样发现其迁移路线?

84、为什么要睡眠?

85、人类为什么会做梦?

86、语言学习为什么存在临界期?

87、信息素影响人类行为吗?

88、一般麻醉剂如何发挥作用?

89、导致精神分裂症的原因是什么?

90、引发孤独症的原因是什么?

91、阿兹海默症患者的生命能够延续多久?

92、致瘾的生物学基础是什么?

93、大脑如何建立道德观念?

94、通过计算机进行学习的极限是什么?

95、有多少个性源于遗传?

96、性别倾向的生物学根源是什么?

97、生命树是生命之间系统关系最好的表达方式吗?

98、地球上有多少物种?

99、什么是物种?

100、横向转移为什么会发生在众多的物种中以及如何发生?

101、谁是世界的共同祖先?

102、植物的花朵如何进化?

103、植物怎样制造细胞壁?

104、如何控制植物生长?

105、为什么所有的植物不能免疫一切疾病?

106、外界压力环境下,植物的变异基础是什么?

107、是什么引起物质消失?

108、能否避免物种消亡?

109、一些恐龙为什么如此庞大?

110、生态系统对全球变暖的反应如何?

111、至今共有多少人种,他们之间有何关联?

112、是什么提升了现代人类的行为?

113、什么是人类文化的根源?

114、语言和音乐演化的根源是什么?

115、什么是人种,人种如何进化?

116、为什么一些国家向前发展,而有些国家的发展停滞?

117、政府高额赤字对国家利益和经济增长速度有什么影响?

118、政治与经济自由密切相关吗?

119、为什么改变撒哈拉地区贫困状态的努力几乎全部失败?

120、有没有简单的方法确定椭圆曲线是否存在无穷多解?

121、霍奇闭链是代数闭链的和吗?

122、数学家将会最终给出Navier-Stokes方程的解吗?

123、庞加莱实验能否确定4维空间的球?

124、黎曼zeta函数的零解都有a+bi形式吗?

125、对粒子物理标准模型研究是否会停止在量子Yang-Mills理论上?
我是小天方夜谭,尽量分享一些自己看到的信息,希望每篇几分钟即可快速看完,欢迎大家关注,谢谢!
-
- 中国导弹之父钱学森有着怎样的传奇人生
-
2026-01-11 03:31:08
-
- 成都市龙泉驿区大面街道及各社区基本情况简介
-
2026-01-11 03:28:54
-
- 成龙:跨越时代的动作之星,演艺生涯的不朽传奇
-
2026-01-11 03:26:40
-
- 博物馆Vol.147 | 南越王博物院
-
2026-01-11 03:24:25
-
- 壁纸系列—文字主题手机壁纸
-
2026-01-10 21:34:17
-
- 北京学慧网络违反消费者权益保护法被罚5000元
-
2026-01-10 21:32:03
-
- 这60个健康知识,医生不会一个个告诉你,看看吧,涨知识
-
2026-01-10 21:29:49
-
- 一禅小和尚精美壁纸
-
2026-01-10 21:27:35
-
- 恐怖搞笑gif动态图片
-
2026-01-10 21:25:20
-
- 刚刚!马化腾在乌镇决定,VR版微信或将到来!
-
2026-01-10 21:23:06
-
- 俄罗斯世界杯前夕 走进萨马拉体育场
-
2026-01-10 21:20:52
-
- 代加工钻石画月入八千?这个“兼职”很诱人,全国300多人被骗
-
2026-01-10 21:18:38
-
- i miss you 我错过你了
-
2026-01-10 21:16:23
-
- 2022年四川美术学院校考考题汇总
-
2026-01-10 21:14:09
-
- 5个方法让声音变得更好听
-
2026-01-10 10:01:35
-
- 3本女追男现言甜宠文,女主会撩会撒娇,高冷男神带回家
-
2026-01-10 09:59:21
-
- 最新百家姓排名你的姓排第几?
-
2026-01-10 09:57:06
-
- 魔哒蒂斯解说上单巨魔锤锤到肉虎的不行
-
2026-01-10 09:54:52
-
- 「青奥会」射击——赛场上舞动的“潘迪”
-
2026-01-10 09:52:38
-
- 最新!石家庄民办初中报名第一天数据汇总来了
-
2026-01-10 09:50:23



otc是什么意思(OTC是什么意思?深入解析OTC市场)
galgame鉴赏:十二魔器之一 重口猎奇作《解体插入新书》
ky是什么梗?ky到底是什么意思?
28位短剧型男,其中最高的192cm,真的是又高又帅又会演!
唐朝刺史是几品?唐朝刺史相当于现在什么官
难得的好小品演员,黄杨 在饭米粒儿中饰演黄小黄
略备薄酒还是略备薄宴 略备薄酒以小酌的意思
玉化砗磲手串一般多少钱?这份价格清单请收好
“最美丈母娘”赵柯的坎坷成名史,和她的心酸情史
《青涩的体验》:深刻描述了青春期的微妙情感